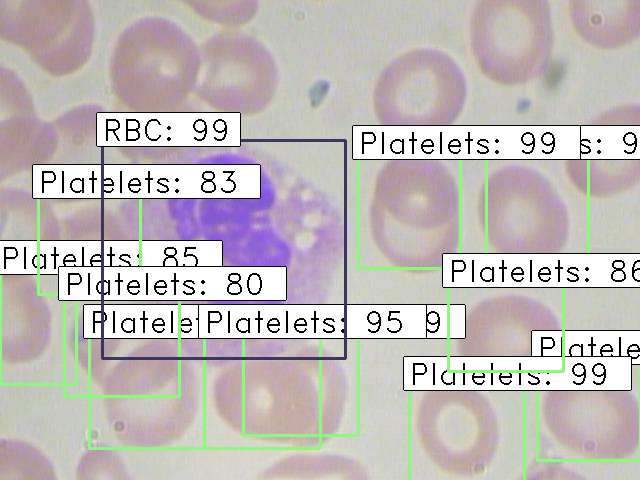
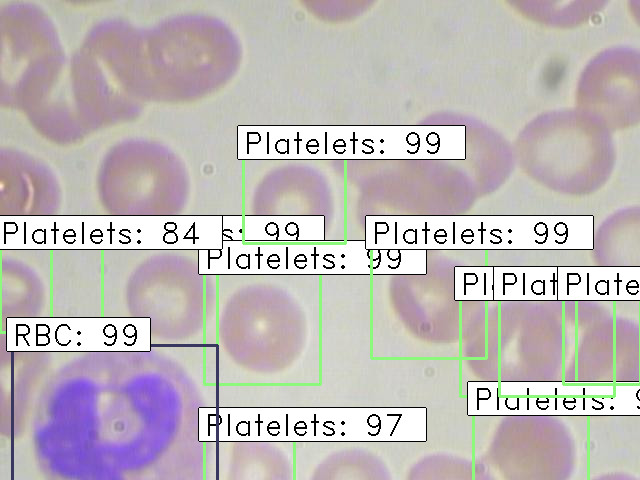
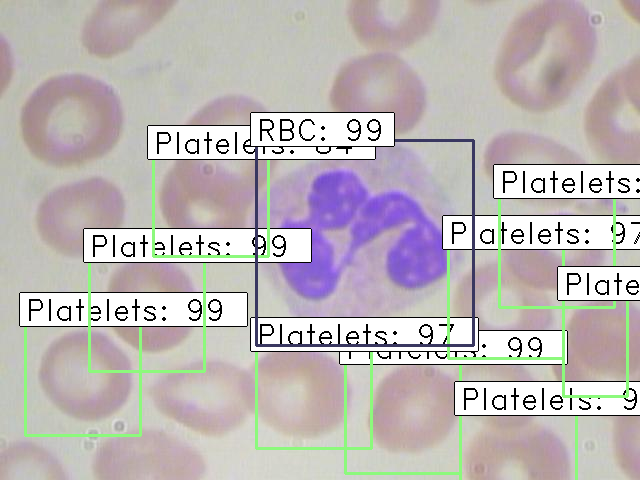

Faster RCNN for Object Detection with Keras
Bài đăng này đã không được cập nhật trong 6 năm
I. Introduction
Faster RCNN - Đây là một thuật toán object detection trong gia đình RCNN( Region-based CNN ) với phiên bản nâng cấp cao hơn so với RCNN và Fast RCNN. So với 2 phiên bản trước, phiên bản này nhanh hơn rất nhiều do có sự tối ưu về mặt thuật toán.
Hãy cùng so sánh một chút giữa RCNN, Fast RCNN và Faster RCNN
- 
Với RCNN
R-CNN sử dụng Selective Search để extract các regions từ image đầu vào và check sự xuất hiện bất kì của object bên trong các box. Từ các regions này, sử dụng CNN cho mỗi region để tìm ra các specific features rồi sử dụng các features này để detect ra các objects.
![]()
 - 
Fast RCN
Fast R-CNN ngược lại, pass toàn bộ image vào mạng CNN thay vì pass từng extract region như R-CNN để sinh ra các ROIs (region of interest). Vì vậy thay vì dùng nhiều models thì nó chỉ cần 1 model duy nhất để extract ra các features từ các regions, phân loại chúng thành các class khác nhau, rồi trả về các bounding boxes tương ứng.
![]()
Tất cả các bước trên đều được run đồng thời vì vậy nó nhanh hơn so với R-CNN, tuy nhiên vẫn là 1 trở ngại với 1 dataset lớn do nó vẫn sử dụng selective search để extract ra các regions.
 - 
Faster RCNN
Faster R-CNN giải quyết được vấn đề của Fast R-CNN bằng cách thay thế
Selective Searchvới RPN (Region Proposal Network)![]()
- Đưa ảnh đầu vào qua mạng CNN để extract ra các features map
 - Apply RPN lên các feature maps để thu được các object proposals
 - Sử dụng ROI pooling lên all các proposals
 - Pass các proposals này qua fully connected layer để phân loại và dự đoán bounding box cho các objects
 
 
II. Implement
1. Dataset
Chúng ta sẽ làm việc trên một healcare dataset có tên là BCCD, mục tiêu ở đây là phát hiện ra những vấn đề bất thường ở trên mạch máu người nhằm phục vụ cho các nghiệp vụ chuẩn đoán trong ý tế. Miêu tả một chút về dataset thì dataset này chứa các ảnh tế báo máu được chụp từ kính hiển vi, nhiệm vụ của chúng ta là phải phát hiện ra tất cả các tế bào Hồng cầu (RBCs), Bạch cầu (WBCs)  và Tiểu cầu (Platelets) trong mỗi ảnh.
Ví dụ:

Mọi người có thể download dataset này tại đây
2. Librabies and frameworks required
Dưới đây là danh sách các libraries và frameworks cần cài đặt:
 pandas
 matplotlib
 tensorflow - 1.8.0
 keras – 2.2.0
 numpy
 opencv-python
 sklearn
 h5py
3. Data Exploration
Hãy xem qua bức ảnh dưới đây để hiểu sơ qua về dataset ta đang có:

Có thể thấy ta đang có 6 columns ở đây, trong đó vai trò của mỗi column như sau:
- filename: chứa tên của ảnh
 - cell_type: 1 trong 3 loại RBC, WBC, Platetet
 - xmin: toạ độ x bottom left của ảnh
 - ymin: toạ độ y bottom left của ảnh
 - xmax: toạ độ x top right của ảnh
 - ymax: toạ độ y top right của ảnh
 
Load thử 1 ảnh lên xem thử:

4. Implementing Faster RCNN
Để mô phỏng thuật toán Faster RCNN, chúng ta sẽ làm theo các bước được mô tả trong respo này .
Với bộ dataset BCCD phía trên, chúng ta cần chuẩn bị data cho việc training. Convert chúng sang 1 file CSV:
%pylab inline
import os, sys, random
import xml.etree.ElementTree as ET
from glob import glob
import pandas as pd
from shutil import copyfile
annotations = glob('BCCD_Dataset-master/BCCD/Annotations/*.xml')
df = []
cnt = 0
for file in annotations:
  prev_filename = file.split('/')[-1].split('.')[0] + '.jpg'
  filename = str(cnt) + '.jpg'
  row = []
  parsedXML = ET.parse(file)
  for node in parsedXML.getroot().iter('object'):
      blood_cells = node.find('name').text
      xmin = int(node.find('bndbox/xmin').text)
      xmax = int(node.find('bndbox/xmax').text)
      ymin = int(node.find('bndbox/ymin').text)
      ymax = int(node.find('bndbox/ymax').text)
  row = [prev_filename, blood_cells, xmin, xmax, ymin, ymax]
  df.append(row)
  cnt += 1
data = pd.DataFrame(df, columns=['filename', 'cell_type', 'xmin', 'xmax', 'ymin', 'ymax'])
data[['filename', 'cell_type', 'xmin', 'xmax', 'ymin', 'ymax']].to_csv('blood_cell_detection.csv', index=False)
Convert lại 1 lần nữa cho chuẩn với format input đầu vào:
import pandas as pd
import matplotlib.pyplot as plt
%matplotlib inline
from matplotlib import patches
train = pd.read_csv('blood_cell_detection.csv')
train.head()
data = pd.DataFrame()
data['format'] = train['filename']
for i in range(data.shape[0]):
  data['format'][i] = 'train_images/' + data['format'][i]
for i in range(data.shape[0]):
  data['format'][i] = data['format'][i] + ',' + str(train['xmin'][i]) + ',' + str(train['ymin'][i]) + ',' + str(train['xmax'][i]) + ',' + str(train['ymax'][i]) + ',' + train['cell_type'][i]
data.to_csv('annotate.txt', header=None, index=None, sep=' ')
Ta cần 1 file config cho quá trình training mode và make predictions. Các bạn có thể down nó tại đây
Tiếp theo chạy lệnh sau để train_model:
python train_frcnn.py -o simple -p annotate.txt
Quá trình train model sẽ take khá nhiều time vì vậy các bạn có thể change lại number epochs (suggest là around 500) hoặc sử dụng lại file weights đã được train ở đây
Sau quá trình training thì bây giờ là lúc make predictions cho tập test, để lưu các images sau khi predict, các bạn vào file test_frcnn.py sau đó
- Bỏ comment: 
cv2.imwrite(‘./results_imgs/{}.png’.format(idx),img) - và comment 2 lệnh cuối này:
 
 # cv2.imshow(‘img’, img)
 # cv2.waitKey(0)
Sau đó chạy lệnh sau để make predictions:
python test_frcnn.py -p test_images
Dưới đây là 1 vài kết quả mà mình thu được:

III. Summary
Trên đây là những gì mình muốn giới thiệu về Faster-RCNN, có khá nhiều bài so sánh giữa R-CNN, Fast R-CNN khá chi tiết trên mạng, các bạn có thể tìm hiểu thêm nha. Cảm ơn mọi người đã đọc bài.
IV. References
https://github.com/ShaoqingRen/faster_rcnn
https://www.analyticsvidhya.com/blog/2018/11/implementation-faster-r-cnn-python-object-detection/
All rights reserved



